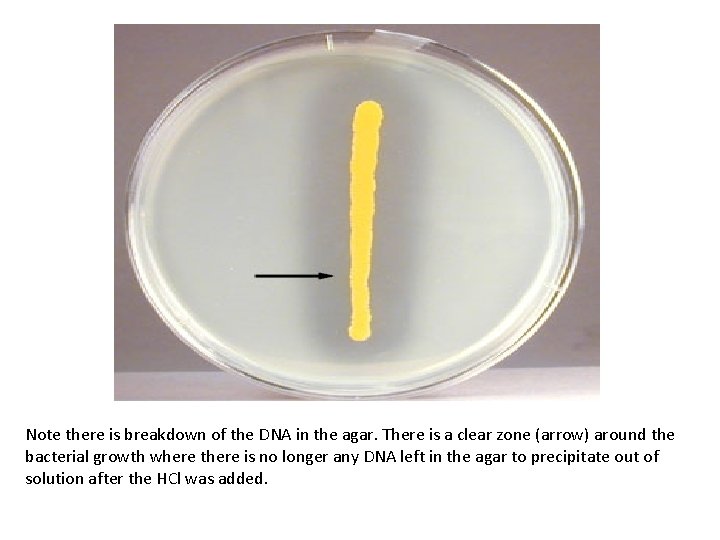
Note there is breakdown of the DNA in the agar. There is a clear

BIOCHEMICAL TEST TO IDENTIFY BACTERIA Prepared by Miss

BIOCHEMICAL TEST TO IDENTIFY BACTERIA Prepared by: Miss Norzawani Jaffar Bsc(Hons) Biomedical Sciences

Learning Outcomes • Able to understand the principle and function of biochemical test; 1. 2. 3. 4. 5. 6. 7. 8. 9. 10. 11. Beta-glucuronidase Bile solubility Catalase Citrate utilization Coagulase DNA-ase Indole Litmus milk decolorization Lysine decarboxylase Oxidase Urease

Introduction • While several commercial system for identifying bacteria are available, these are often difficult to obtain or too expensive to use in developing countries. • This subunit includes a range of conventional biochemical test and tablet identification test which most district laboratories will be able to perform.

TEST PURPOSE Beta-glucuronidase To identify E. coli Bile Solubility To differentiate S. pneumoniae from other alpha-haemoytic streptococci Catalase Citrate utilization To differentiate staphylococci from streptococci To differentiate enterobacteria Coagulase To identify S. aureus DNA-ase To help identify S. aureus Indole To differentiate Gram negative rods, particularly E. coli

TEST PURPOSE Litmus milk decolorization To help identify Enterococcus and some clostrodia Oxidase To help identify Neisseria, Pasteurella, Vibrio, Pseudomonas To help identify Proteus, Morganella, Y. enterocolitica, H. pylori Urease Lysine decarboxylase To assist in the identification os Salmonella and shigella

Bile Solubility Test • To differentiate S. pneumoniae, which is soluble in bile and bile salt, from other alpha-hemolytic streptococci (viridans streptococci) which are insoluble. • PRINCIPLE: – A Heavy inoculum of the test organism is emulsified in physiological saline and the bile salt sodium deoxycholate is added. This dissolves S. pneumoniae as shown by a clearing of the turbidity with in 10 -15 minutes. Viridans and other streptococci are not dissolved and therefore there is no clearing of the turbidity.


Catalase test • Used to differentiate those bacteria that produce the enzyme catalase, such as staphylococci, from non-catalase producing bacteria such as streptococci. • PRINCIPLE: – Catalase act as a catalyst in the breakdown of hydrogen peroxide to oxygen and water. An organism is tested for catalase production by bringing it into contact with hydrogen peroxide. Bubbles of oxygen are released if the organism is a catalase producer. The culture should not be more than 24 hrs old.

Most aerobic organsims will display (+) results. e. g. Staphyloccocus aureus. Some anaerobic organisms will display (-) results, indicating that they do not produce catalase to prevent oxygen accumulation. Why? Because since oxygen is totally not used for survival of these organisms, they do not have the ability to produce catalase.

Citrate Utilization Test • Purpose: The citrate utilization test is used to determine the ability of an organism, using the enzyme citrase, to use citrate as its sole carbon source • Used occasionally to assist in the identification of enterobacteria.

Coagulase Test • This test is used to identify S. aureus which produces the enzyme coagulase. • PRINCIPLE: – Coagulase cause plasma to clot by converting fibrinogen to fibrin. Two types of coagulase are produced by most strains of S. aureus • Free coagulase which converts fibronogen to fibrin by activating a coagulase-reacting factor present in plasma. Free coagulase is detected by clotting in the test tube. • Bound coagulase (clumping factor) which converts fibrinogen directly to fibrin without requiring a coagulase-reacting factor. It can be detected by the clumping pf bacterial cells in the rapid slide test.



• A tube test must be performed when the result of a slide test is not clear, or when the slide test is negative and Staphylococcus has been isolated from a serious infections. • Before performing a coagulase test, examine a Gram stained smear to confirm that the organism is a Gram positive coccus.

DNA-ase test • Used in the identification of S. aureus which produces deoxyribonuclease (DNA-ase) enzymes. The DNA-ase test is particularly useful when plasma is not available to performed a coagulase test or when the results of a coagulase test are difficult to interpret. • PRINCIPLE: – Deoxyribonuclease hydrolyzes deoxyribonucleic acid(DNA). The test organism is cultured on a medium which contains DNA. After overnight incubation, the colonies are tested for DNA-ase-production by flooding the plate with a weak hydrochloric acid solution. The acid precipitates unhydrolyzed DNA-ase producing colonies are therefore surround by clear areas due to DNA hydrolysis.
Note there is breakdown of the DNA in the agar. There is a clear zone (arrow) around the bacterial growth where there is no longer any DNA left in the agar to precipitate out of solution after the HCl was added.

Indole Test • Testing for indole production is important in the identification of enterobacteria. Most strains of E. coli, P. vulgaris, P. rettgeri, M. morganii, and Providencia species break down the amino acid tryptophan with the release of indole. • PRINCIPLE: – The test organism is cultured in a medium which contains tryptophan. Indole production is detected by Kovac’s or Ehrlich’s reagent which contains 4 (p)-dimethylaminobenzaldehyde. This reacts with the indole to produce a red coloured compound. Kovac’s reagent is recommended in preference to Ehrlich’s reagent for the detection of indole from enterobacteria.

Result: Red surfeca layer------ positive indole test No red layer ---------- negative indole test.

Litmus Milk Decolorization test • A rapid and inexpensive technique to assist in the identification of enterococci. • It is based on ability of most strains of Enterococcus sp to reduce litmus milk by enzyme action as shown by decolorization of the litmus. • PRINCIPLE – A heavy inoculum of the test organism is incubated for up to 4 hours in a tube containing litmus milk. Reduction of litmus milk is indicated by a change in colour of the medium from mauve to white or pale yellow.

Result: White or pale yellow-pink colour--------suggestive of Enterococcus No change or a pink colour------- probably not Enterococcus

Oxidase Test • The oxidase test is used to assist in the identification of Pseudomonas, Neisseria, Vibrio, Brucella, Pasteurealla species, all of which produce the enzyme cytochrome oxidase. • PRINCIPLE – A piece of filter paper is soaked with a few drops of oxidase reagent. A colony of the test organism is then smeared on the filter paper. – When the organism is oxidase-producing, the phenylenediamine in the reagent will be oxidized to a deep purple colour.

Result: Blue-purple colour---------positve oxidase test(within 10 seconds) No blue-purple colour-------Negative oxidase test (within 10 seconds) Note!: Ignore any blue-purple colour that develops after 10 seconds.

Motility agar • is a differential medium used to determine whether an organism is equipped with flagella and thus capable of swimming away from a stab mark. • The results of motility agar are often difficult to interpret. • Generally, if the entire tube is turbid, this indicates that the bacteria have moved away from the stab mark (are motile). • The organisms in the two tubes pictured on the right are motile. If, however, the stab mark is clearly visible and the rest of the tube is not turbid, the organism is likely nonmotile (tube pictured on the left).


Urease test • This test is used to identify bacteria capable of hydrolyzing urea using the enzyme urease. • It is commonly used to distinguish the genus Proteus from other enteric bacteria. • The hydrolysis of urea forms the weak base, ammonia, as one of its products. • This weak base raises the p. H of the media above 8. 4 and the p. H indicator, phenol red, turns from yellow to pink. • Proteus mirabilis is a rapid hydrolyzer of urea (center tube pictured here). The tube on the far right was inoculated with a urease negative organism and the tube on the far left was uninoculated.


END Q&A

Take note from http: //norazlicucst. weebly. com MICROBIOLOGY II: TOPIC 2
- Slides: 28